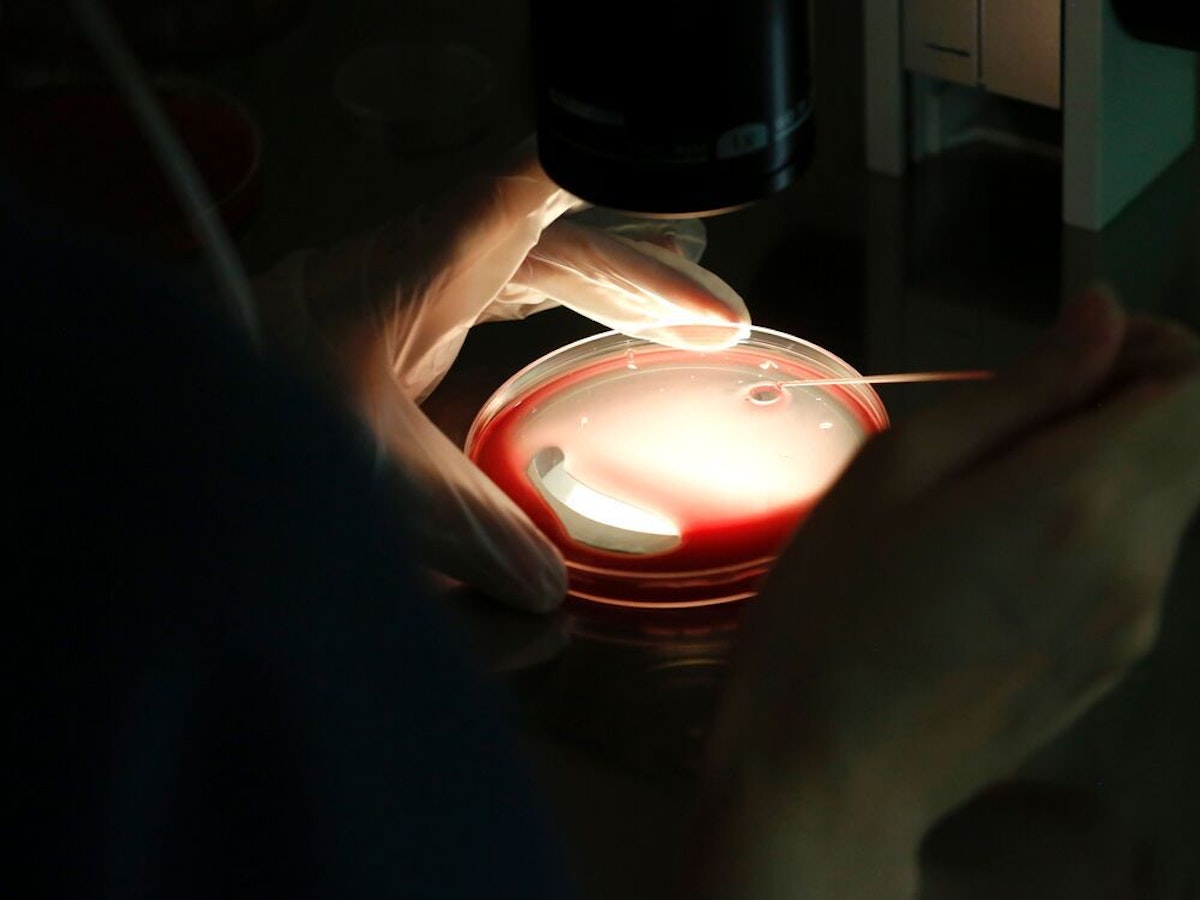

Fertility benefits are the new must-have perk companies are using to find and keep workers
Once limited to tech companies, such benefits are now being offered by food, retail, automotive and manufacturing firms

Once limited to tech companies, such benefits are now being offered by food, retail, automotive and manufacturing firms